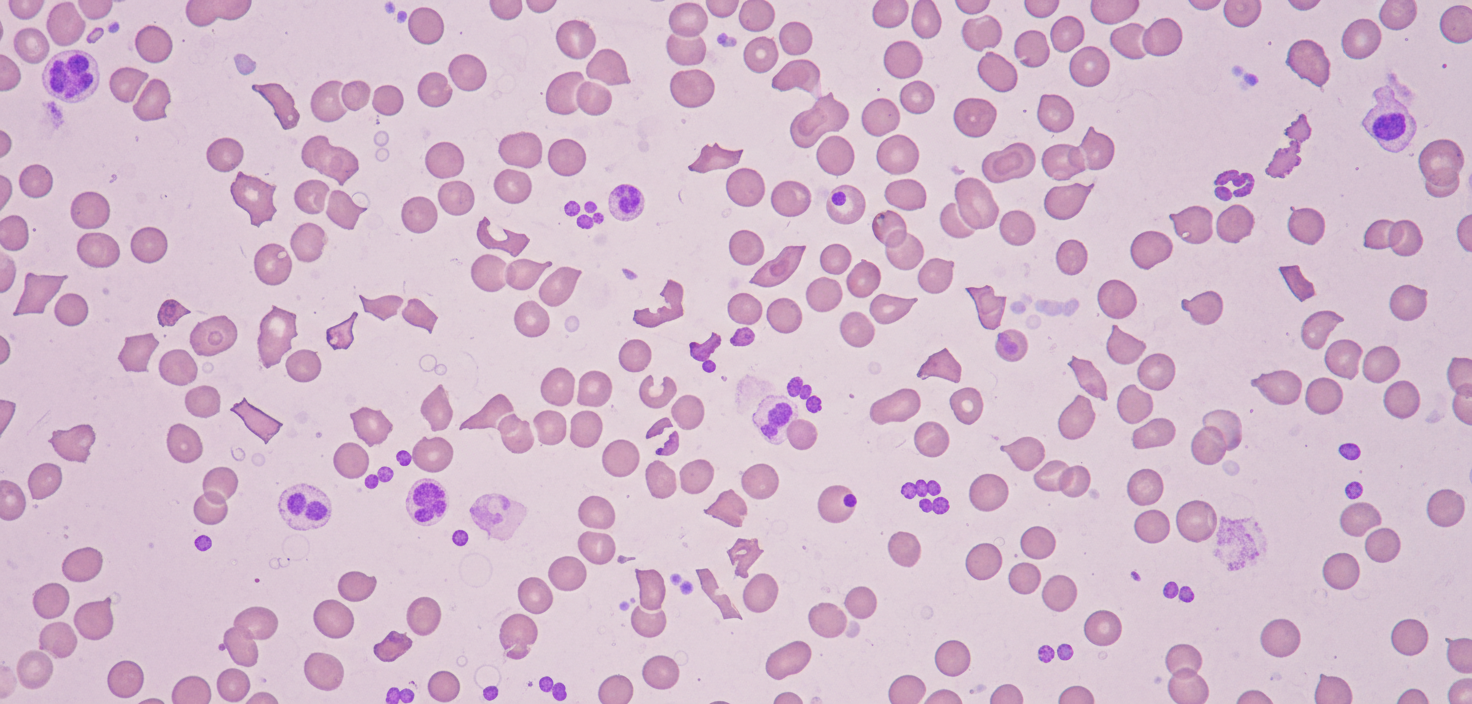
Image for question 64

Infectious Disease — MCQs

On this page
A 9-year-old boy is brought to the emergency department by his mother. She says that he started having “a cold” yesterday, with cough and runny nose. This morning, he was complaining of discomfort with urination. His mother became extremely concerned when he passed bright-red urine with an apparent blood clot. The boy is otherwise healthy. Which of the following is the most likely underlying cause?
An 11-year-old boy is brought to the emergency department because he was found to have severe abdominal pain and vomiting in school. On presentation, he is found to be lethargic and difficult to arouse. His parents noticed that he was eating and drinking more over the last month; however, they attributed the changes to entering a growth spurt. Physical exam reveals deep and rapid breathing as well as a fruity odor on his breath. Which of the following sets of labs would most likely be seen in this patient?
A 15-month-old boy presents to his family physician after being brought in by his mother. She is concerned that her son has been sick for more than 5 days, and he is not getting better with home remedies and acetaminophen. On examination, the child has a sore throat and obvious congestion in the maxillary sinuses. His temperature is 37.6°C (99.6°F). An infection with Haemophilus influenzae is suspected, and a throat sample is taken and sent to the laboratory for testing. The child is at the lower weight-for-length percentile. His history indicates he previously had an infection with Streptococcus pneumoniae in the last 4 months, which was treated effectively with antibiotics. While waiting for the laboratory results, and assuming the child’s B and T cell levels are normal, which of the following diagnoses is the physician likely considering at this time?
A 3-year-old girl is brought to the emergency department because of chest pain for 2 hours. Eight days ago, she was admitted to the hospital for treatment of low-grade fever, malaise, and sore throat. The hospitalization was complicated by pharyngitis with pseudomembrane formation and severe cervical lymphadenopathy briefly requiring intubation. She has not received any routine childhood vaccinations. Serum studies show elevated cardiac troponins. An ECG shows diffuse T wave inversions and prolonged PR interval. Which of the following preventative measures would most likely have prevented this patient's cardiac symptoms?
A 4-year-old girl is brought to the physician because of diarrhea and vomiting for 5 days. Vaccinations are up-to-date. She appears pale and irritable. Her vital signs are within normal limits. Examination shows petechiae on her trunk and extremities. Abdominal examination shows diffuse abdominal tenderness with hyperactive bowel sounds. The remainder of the exam shows no abnormalities. Laboratory studies show: Hemoglobin 8 g/dL Leukocyte count 17,000/mm3 Platelet count 49,000/mm3 Serum Creatinine 1.6 mg/dL Lactate dehydrogenase 300 U/L Coagulation studies are normal. A peripheral blood smear is shown. Which of the following is the most likely underlying cause of these findings?
A 9-year-old boy is brought to your office due to nausea and vomiting. He had 4 episodes of non-bloody and non-bilious emesis over the last 24 hours. He denies any diarrhea or changes in his diet; however, his best friend at school recently had viral gastroenteritis and his mother is concerned that he has the same bug. She notes that he has been drinking more water than usual and wet his bed twice over the last two weeks. He is otherwise healthy and is not taking any medications. On physical exam his temperature is 99°F (37.2°C), blood pressure is 100/70 mmHg, pulse is 112/min, respirations are 26/min, and pulse oximetry is 99% on room air. He has lost 10 pounds since his previous visit 6 months ago. There is diffuse, mild abdominal tenderness to palpation. The most likely disease process responsible for this patient's symptoms is associated with which of the following?
You are seeing a 4-year-old boy in clinic who is presenting with concern for a primary immune deficiency. He has an unremarkable birth history, but since the age of 6 months he has had recurrent otitis media, bacterial pneumonia, as well as two episodes of sinusitis, and four episodes of conjunctivitis. He has a maternal uncle who died from sepsis secondary to H. influenza pneumonia. If you drew blood work for diagnostic testing, which of the following would you expect to find?
Two months after giving birth to a boy, a 27-year-old woman comes to the physician with her infant for a well-child examination. She was not seen by a physician during her pregnancy. Physical examination of the mother and the boy shows no abnormalities. Laboratory studies show elevated titers of hepatitis B surface antigen in both the mother and the boy. Which of the following statements regarding the infant's condition is most accurate?
A 2-year-old girl is brought to the emergency department in the middle of the night because of difficulties breathing. Her parents say that the breathing noises have become progressively worse throughout the day and are mainly heard when she inhales. They say that a change in posture does not seem to have any effect on her breathing. For the last three days, she has also had a runny nose and a harsh cough. She has not had hemoptysis. The parents are worried she may have accidentally swallowed something while playing with her toys, since she tends to put small things in her mouth. Her immunizations are up-to-date. She appears lethargic, and high-pitched wheezing is heard at rest during inhalation. Her skin tone is normal. Her temperature is 38.7°C (101.7°F), pulse is 142/min, respirations are 33/min, and blood pressure is 110/70 mm Hg. Pulse oximetry on room air shows an oxygen saturation of 97%. Examination shows supraclavicular and intercostal retractions. There is diminished air movement bilaterally. An x-ray of the neck and upper chest is shown. Which of the following is the most appropriate next step in management?

A 4-year old boy is brought to the emergency department with fever, painful swallowing, headache, and neck spasm that began shortly after waking up. He has had a sore throat over the last week that acutely worsened this morning. He has no history of serious illness and takes no medications. He lives at home with his mother. His older brother has asthma. His immunizations are up-to-date. He appears acutely ill. His temperature is 38.4°C (101.2°F), pulse is 95/min, respirations are 33/min, and blood pressure is 93/60 mm Hg. Examination shows drooling. The neck is stiff and extension is limited. Respirations appear labored with accessory muscle use. Inspiratory stridor is heard on auscultation of the chest. Cardiac examination shows no abnormalities. Oropharyngeal examination shows a bulge in the posterior pharyngeal wall. Intravenous access is obtained and laboratory studies are ordered. Which of the following is the most appropriate next step in the management of this patient?
Practice by Chapter
Common childhood exanthems
Practice Questions
Pediatric respiratory infections
Practice Questions
Pediatric gastrointestinal infections
Practice Questions
Urinary tract infections in children
Practice Questions
Bone and joint infections
Practice Questions
Central nervous system infections
Practice Questions
Pediatric tuberculosis
Practice Questions
Pediatric HIV
Practice Questions
Recurrent infections evaluation
Practice Questions
Fever of unknown origin approach
Practice Questions
Emerging infectious diseases in children
Practice Questions
Post-infectious immune complications
Practice Questions
Antimicrobial resistance in pediatrics
Practice Questions
Want unlimited practice?
Get full access to all questions, explanations, and performance tracking.
Scan to download app
